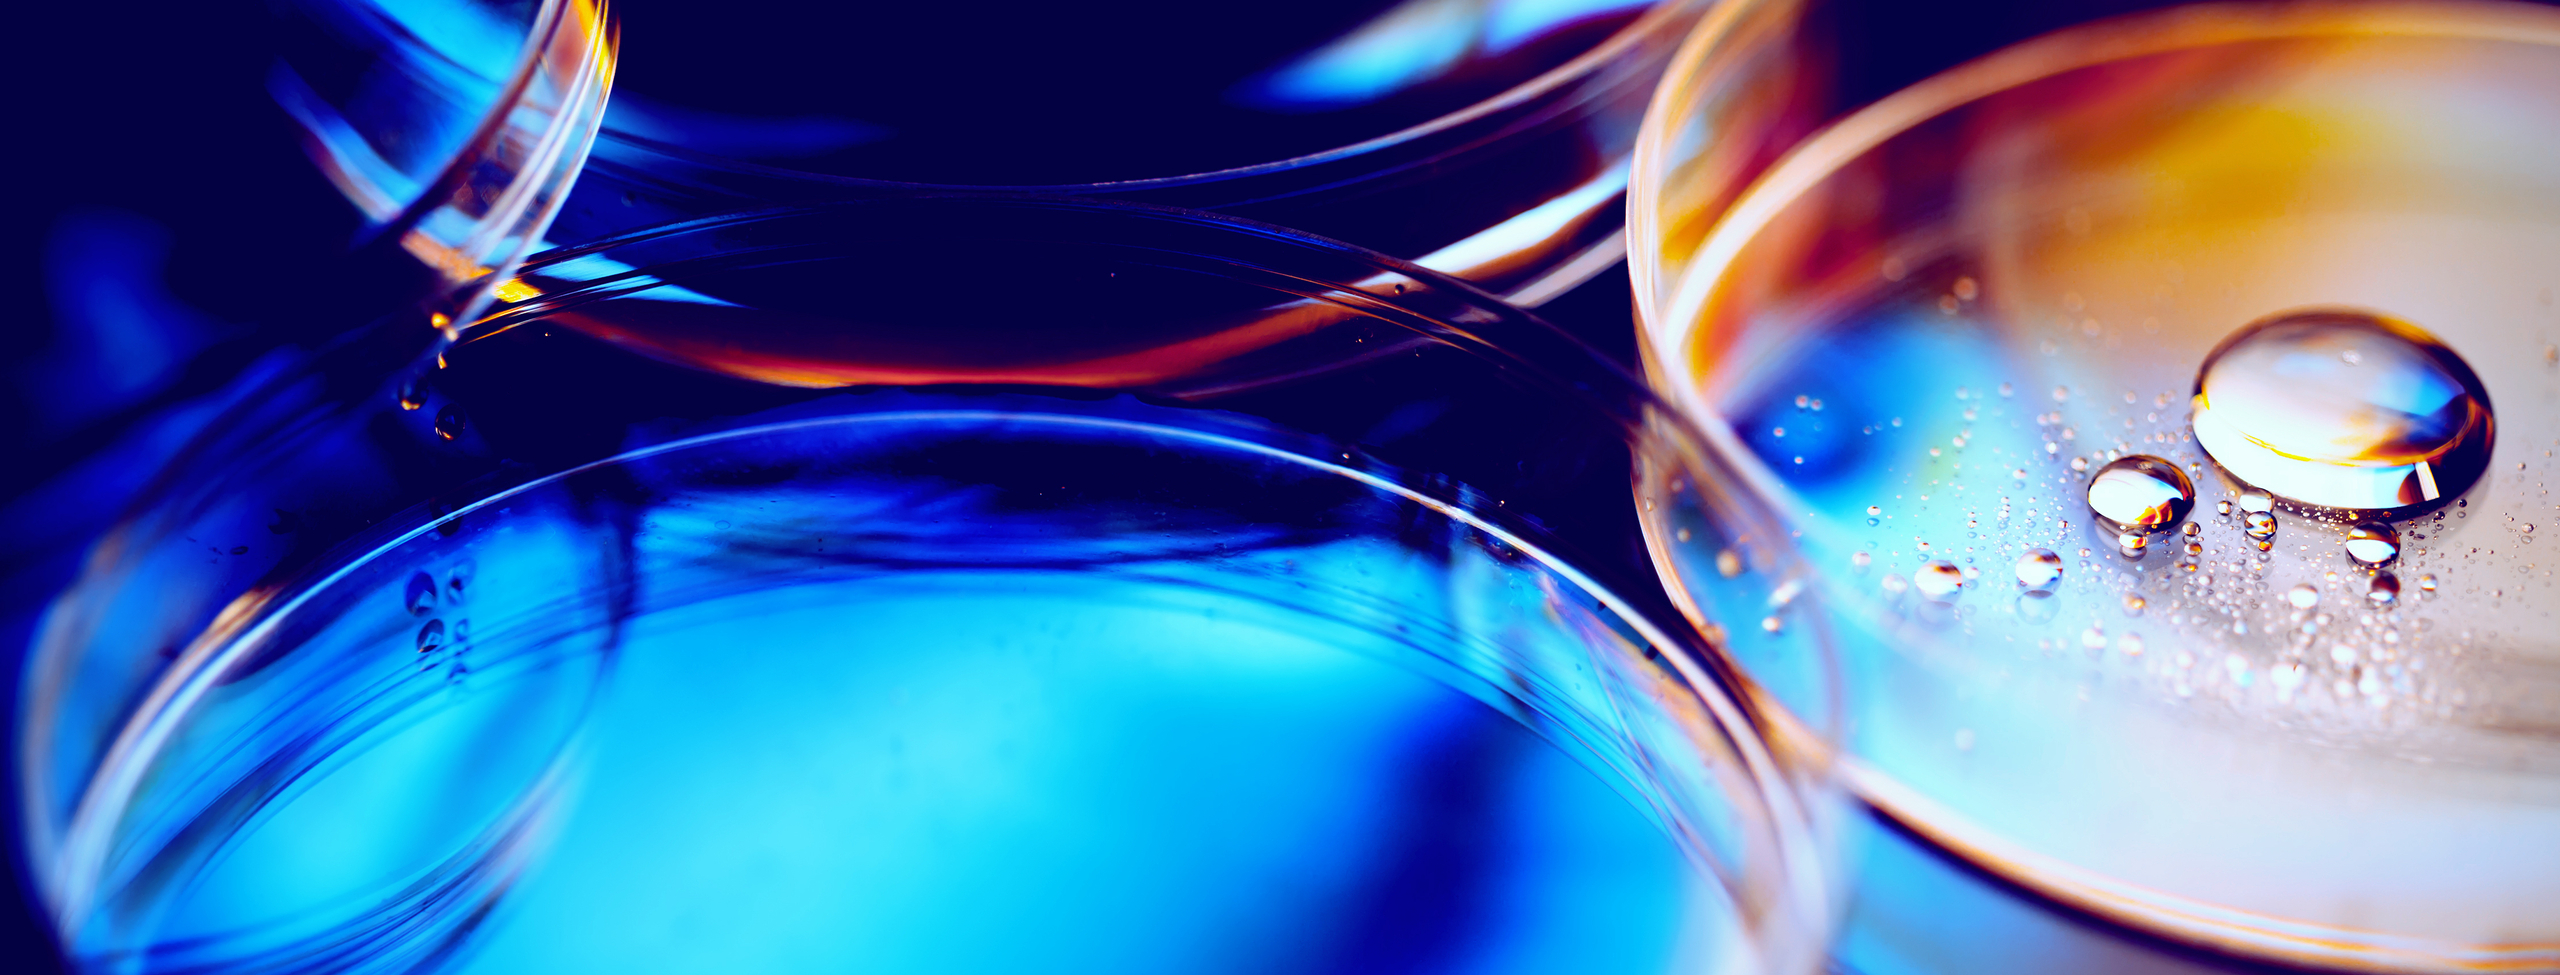
FDA Regulatory News and Trends

Strategic guidance for responding to evolving regulations
Get timely guidance on the rapidly changing legal and regulatory environment shaped by the current administration and congressional priorities.
Drawing on Senator Burr’s deep experience and insider perspective, this webcast series offers actionable insights into Capitol Hill developments that impact businesses and stakeholders across industries.
Stay informed on emerging legislation, regulatory updates, and strategic considerations to help you anticipate and adapt to policy changes.
To learn more about our Regulatory and Government Affairs practice, visit dlapiper.com or contact Che Webb.

Upcoming sessions
Delivering insider perspectives, each episode is built for the moment: responsive to fast‑moving developments and the real‑time questions organizations are asking.
Join us as we unpack the regulatory shifts and policy changes shaping business.
- June 16: The US regulatory outlook, and insights from the EU with Richard Sterneberg, Global Co-Chair, Government Affairs and Public Policy

May 18, 2026 Session Recap
-
CISA remains a key resource for organizations looking to strengthen cyber preparedness.
-
Geopolitical volatility is increasing cyber risk and raising the stakes for business continuity planning.
-
Leadership uncertainty at FDA and HHS may delay decisions that matter to regulated businesses.
-
Now is the time to review recovery plans, backups, and critical third-party dependencies.
-
Regular cyber training and employee awareness remain essential first-line defenses.
Session Takeaways

April 13 , 2026
This Office Hours session focused on near‑term policy and political developments in Washington, with particular attention to unresolved healthcare issues, fiscal pressures, and the compressed legislative window ahead of the midterm elections. Senator Burr and guests discussed what these dynamics mean for Congress, regulated industries, and organizations planning advocacy and risk mitigation strategies.
Key takeaways
- The future of Affordable Care Act subsidies remains uncertain, with consensus leaning toward a short‑term or one‑year extension rather than a permanent solution.
- Healthcare policy is expected to be a central issue in the upcoming midterm elections, shaping legislative priorities and political messaging.
- A narrow legislative window early in the year increases pressure on Congress to act quickly before election‑year dynamics stall progress.
- Drug pricing and life sciences regulation, including market and reimbursement pressures, continue to be active policy areas with significant implications for industry stakeholders.
- Broader budget and fiscal negotiations, including the risk of funding disruptions, remain a recurring source of uncertainty for federal agencies and regulated sectors.
To gain access to the recording of this conversation, reach out to Che Webb.

March 18, 2026
This Office Hours session highlights key updates on global tensions, Homeland Security funding challenges, and the fast‑evolving implementation of the CHIPS Act across administrations. It also explores how semiconductor manufacturing, advanced chips, and data center infrastructure shape U.S. competitiveness, national security, and the future of AI‑powered technology.
Key Takeaways
- Iran’s escalating crisis is dominating U.S. foreign policy, increasing cyberattack risks and overshadowing updates on Ukraine, Gaza, and domestic security issues.
- Homeland Security remains partially shut down due to stalled funding negotiations, creating major concerns during an active period of global conflict.
- The CHIPS Act is shifting toward faster, direct funding for semiconductor and AI companies, with the Trump administration emphasizing financial returns and rapid industry investment.
- CHIPS program teams are under pressure to move quickly, balancing the need for speed with scientific rigor, strong evaluation processes, and responsible use of federal funding.
- Advanced chips and wafer production are critical for powering AI and data centers, making domestic semiconductor capacity essential for energy efficiency, infrastructure resilience, and long‑term economic security.
To gain access to the recording of this conversation, reach out to Che Webb.

February 17, 2026
This Office Hours session examines how congressional investigations have accelerated, become more aggressive, and increasingly pose reputational risk, requiring organizations to prepare well before any inquiry begins.
Key Takeaways
- Investigations are faster and escalate quickly. Committees now move rapidly from information requests to subpoenas, often without extended negotiation or warning.
- Politics and public visibility drive scrutiny. Investigations are shaped by policy priorities, election cycles, and the need for public narratives, not just legislative oversight.
- Reputational risk often outweighs legal risk. Organizations should pre‑identify decision‑makers, response protocols, and privileged communication structures before an inquiry arises.
- AI is accelerating oversight. Artificial intelligence is increasing the speed, scale, and sophistication of investigations by enabling rapid document analysis and narrative formation.
To gain access to the recording of this conversation, reach out to Che Webb.
More from DLA Piper

Report download
FDA in Focus: 2025 review and 2026 outlook
In 2025, FDA concentrated on rebuilding and modernizing its internal infrastructure amid unprecedented organizational and leadership changes. Against the backdrop of a significant reduction in force, shifting regulatory philosophies, and evolving policy priorities, the Agency focused on strengthening food safety, advancing medical product innovation, and enhancing oversight across its programs.
Consumer Goods | Speaker Series
Stay ahead of the curve with these CLE webinars on today’s most pressing regulatory issues related to Consumer Goods.
Designed for regulatory professionals, compliance officers, legal counsel, and business leaders in consumer goods and retail.
- Expert Perspectives: Hear from leading practitioners on topics shaping the regulatory landscape.
- Deep-Dive Sessions: Explore critical areas such as FTC enforcement trends, arbitration developments, post-acquisition integration risks, extended producer responsibility (EPR), and M&A compliance considerations.
- Practical Guidance: Gain strategies to mitigate risk and ensure compliance in a rapidly evolving market.
Stay Informed: FDA Regulatory News and Trends
Keep pace with the latest developments impacting the life sciences and healthcare sectors. DLA Piper’s FDA Regulatory News and Trends provides timely insights on:
- Policy Shifts & Guidance Updates: Understand evolving FDA regulations and compliance expectations.
- Enforcement Priorities: Learn what recent actions signal for manufacturers and stakeholders.
- Emerging Issues: Explore topics such as product approvals, labeling requirements, and risk management strategies.
This resource is essential for regulatory professionals, legal counsel, and industry leaders seeking clarity in a complex regulatory environment.